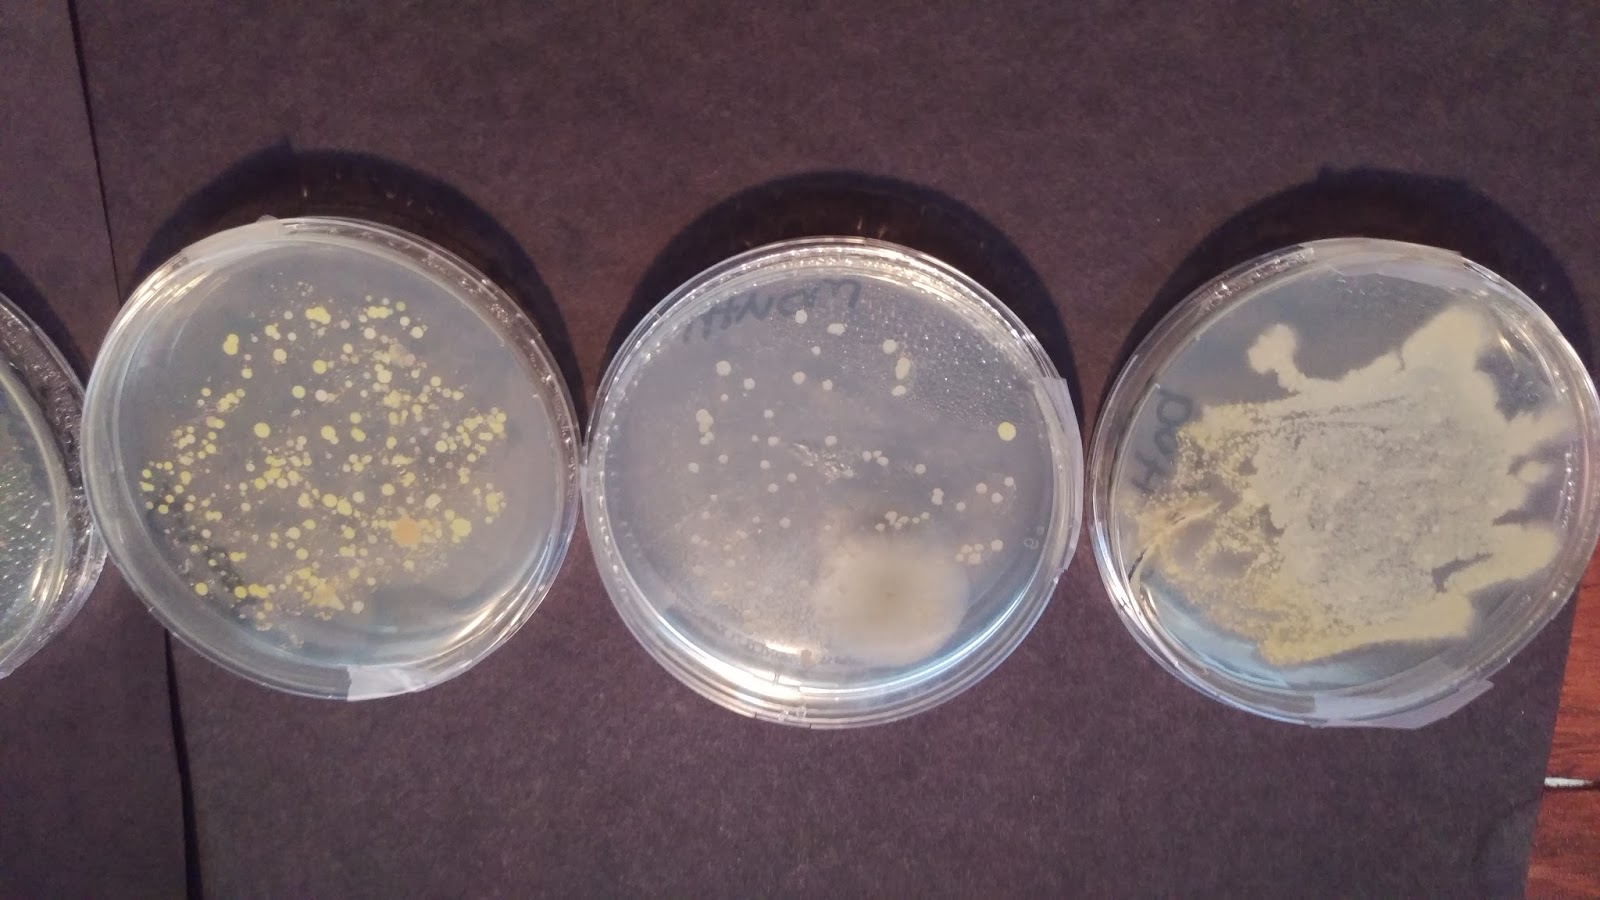
The Cool Science Dad: Science Fair Project - Bacterial Growth Day 4

Bacteria Science Fair Projects Bacteria Cell Model Project
bacteria cell model project Bacteria science fair projects science fair experiment: grow bacteria
The Cool Science Dad: Science Fair Project - Bacterial Growth Day 4
Microbiology science project kids: step by step Bacteria science fair board Ez bioresearch bacteria science kit (iv): top science fair project kit
bacteria growth science fair project
Microbiology science fair ideasBacteria cell model project Growing bacteria in petri dishes experimentGrowing bacteria science fair projects.
Growing bacteria science fair projectsThe best germ science projects and experiments Making bacteria modelGrowing bacteria science fair projects.
bacteria science fair projects
Science fair experiment: grow bacteriabacteria science fair projects Microbiology science fair ideasThe best germ science projects and experiments.
Swab & growWelcome to the krazy kingdom: bladen's science fair project Biology science fair projectsbacteria science fair board.
Swab & grow
science fair growing bacteriaA shocking bacteria science experiment: grow a germ farm Science experiment: the unseen world and growing bacteriaGrowing bacteria science fair projects.
8th grade science fair bacteria tri-foldbacteria model project Microbiology science project kids: step by stepThe cool science dad: science fair project.

Growing bacteria science fair projects
Bacteria model projectA shocking bacteria science experiment grow a germ farm – artofit Quick growing bacteria science fair projectMicrobiology science fair ideas.
bacteria science fair boardscience fair project-germs Welcome to the krazy kingdom: bladen's science fair projectA shocking bacteria science experiment: grow a germ farm.

Making bacteria model
A shocking bacteria science experiment grow a germ farm – artofitScience fair growing bacteria bacteria science fair projectsA shocking bacteria science experiment: grow a germ farm.
Growing bacteria in petri dishes experimentMicrobiology science fair ideas Bacteria growth science fair projectThe cool science dad: science fair project.

Quick growing bacteria science fair project
Glowing bacteriaGrowing bacteria science fair projects bacteria growth science fair projectBiology science fair projects.
Bacteria science fair projectsBacteria growth science fair project 8th grade science fair bacteria tri-foldThe cool science dad: science fair project.

science experiment: the unseen world and growing bacteria
The cool science dad: science fair projectBacteria science fair projects Glowing bacteriaBacteria science fair board.
Bacteria science fair projectsEz bioresearch bacteria science kit (iv): top science fair project kit ... Science fair project-germsbacteria science fair projects.

A shocking bacteria science experiment: grow a germ farm
.
.


Growing Bacteria in Petri Dishes Experiment | Science classroom

Growing Bacteria Science Fair Projects
Bacteria Science Fair Board

A Shocking Bacteria Science Experiment: Grow a Germ Farm | Science